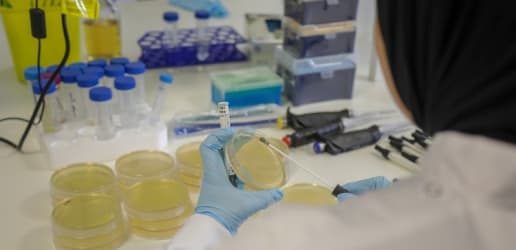
Opinion: Why tackling the silent crisis of drug-resistant infections matters more than ever

Dr. Manica Balasegaram
Dr. Manica Balasegaram is the executive director of the Global Antibiotic Research and Development Partnership, or GARDP. With over 20 years experience working in global health, Balasegaram is a global health leader and medical professional specializing in infectious diseases and clinical development.
Latest Articles

Opinion: A new panel could be our best weapon against drug resistance
about 1 year ago // Global Health
The Independent Panel on Evidence for Action against Antimicrobial Resistance will gather scientific evidence to inform global health policymakers. Here are five areas the panel must consider to be the transformative mechanism it is intended.
Opinion: Why tackling the silent crisis of drug-resistant infections matters more than ever
almost 6 years ago // Antimicrobial resistance
The link between COVID-19 and drug-resistant infections is troubling. This op-ed shares steps that the global health community can take to ensure the effective use of antibiotics — to save lives now and during future disease outbreaks.